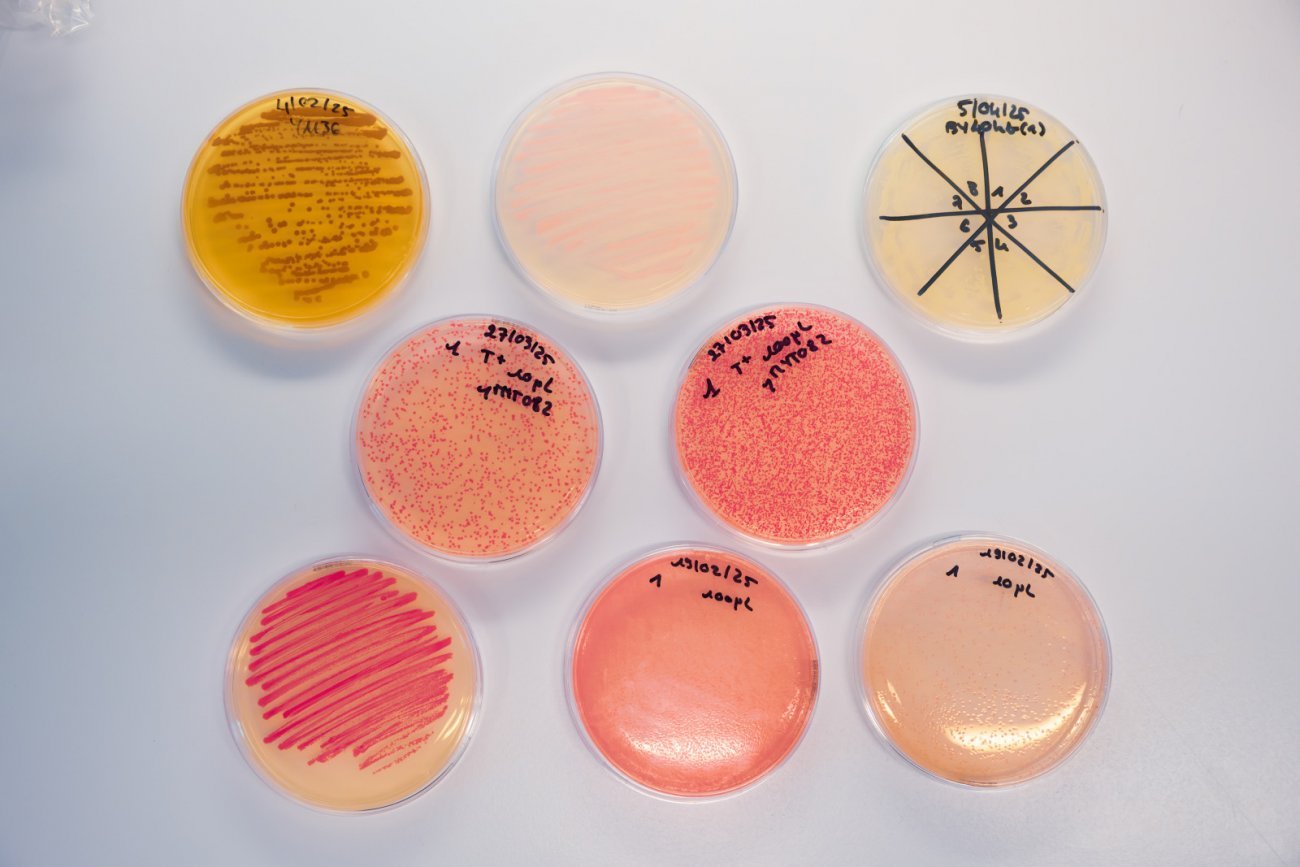
Différentes boites de Petri avec levures et bactéries Différentes boites de Petri avec levures et bactéries

Résistance aux antimicrobiens : enrayer la menace sanitaire
Sommaire
Dossier - Résistance aux antimicrobiens : enrayer la menace sanitaire
- Les microbes pathogènes sont de plus en plus résistants
- La menace d’une crise sanitaire majeure et mondiale est désormais une réalité
- L’exemple du virus Monkeypox et la résistance au Tecovirimat
- L’exemple du champignon Aspergillus : une résistance venue des champs
- L’artémisinine en difficulté contre des parasites de plus en plus résistants au paludisme
- Comment inverser la tendance de dissémination de la résistance aux antimicrobiens ?
Comprendre - Les principaux antimicrobiens et les maladies combattues
Coqueluche - Résistance inédite aux antibiotiques
Champignons - Candida auris : l’ennemi invisible des hôpitaux
Dès la fin du XIXe siècle, Louis Pasteur a démontré que les microbes sont partout, dans l’eau, dans l’air, sur les objets, sur la peau… et que certains d’entre eux sont responsables de maladies. Ces microbes pathogènes sont classés en quatre grandes familles, chacune composée de milliers d’espèces : les bactéries, les virus, les parasites et les champignons. Pour lutter contre les maladies qu’ils portent, des médicaments et traitements antimicrobiens ont été mis au point par les scientifiques et les laboratoires pharmaceutiques. Les plus connus sont les antibiotiques contre les maladies d’origine bactérienne. Mais la famille des antimicrobiens compte aussi les antiviraux (contre les virus), les antiparasitaires (contre les parasites ou protozoaires) et enfin les antifongiques (contre les champignons).
Avec des millions de vies sauvées chaque année, les antimicrobiens ont rempli un rôle essentiel dans la qualité de la santé humaine.
Les microbes pathogènes sont de plus en plus résistants
La Résistance aux Anti-Microbiens (RAM) survient lorsque les bactéries, les virus, les champignons et les parasites évoluent au fil du temps et ne réagissent plus aux médicaments, rendant plus difficile le traitement des infections et augmentant le risque de propagation des maladies.
Concernant les antibiotiques, la résistance est devenue un problème de santé publique majeur depuis leur introduction dans les années 40 et leur usage massif. Cette antibiorésistance s’est accélérée avec la surconsommation des antibiotiques en médecine humaine, vétérinaire et en agriculture. Les bactéries ont alors développé de redoutables stratégies pour survivre à ces médicaments : destruction ou modification de l’antibiotique par des enzymes, protection de la partie de la bactérie ciblée, expulsion de l’antibiotique par des systèmes de pompes, etc. : tout un arsenal que les bactéries peuvent se transmettre, permettant la propagation de « superbactéries ». Si la résistance aux antibiotiques est un phénomène inévitable son explosion actuelle est largement due à l’activité humaine. Aujourd’hui, la RAM dépasse largement le cadre des antibiotiques. Le phénomène menace tous les traitements : antiviraux (avec des souches de VIH résistantes), antifongiques (face au champignon émergent Candida auris), et antipaludiques (comme l’artémisinine inefficace contre certaines formes de paludisme).

Les principaux antimicrobiens et les maladies combattues
- Les antibiotiques contre les maladies bactériennes : pneumonies, bronchites, otites, méningites, infections urinaires, septicémies, chlamydiose, gonorrhée (blennorragie), syphilis, maladie de Lyme, tuberculose, lèpre, etc.
- Les antiviraux contre les maladies virales : VIH, grippe, herpès, varicelle-zona, cytomégalovirus, hépatites B et C, bronchiolite à VRS, Covid-19, etc.
- Les antipaludiques contre le paludisme, antihelminthiques contre les vers intestinaux et antiprotozoaires contre les maladies dues aux amibes, giardia, leishmania, trypanosomes, toxoplasme, etc.
- Les antifongiques contre les maladies dues aux champignons : mycoses, infections surtout fréquentes sur la peau, les cheveux, les ongles, les muqueuses et les organes génitaux ; nombreuses maladies affectant les productions agricoles, etc.

Résistance inédite aux antibiotiques
En 2024, la France a enregistré une épidémie majeure de coqueluche, estimée à 150 000 cas, un niveau inédit depuis plusieurs décennies. Selon Sylvain Brisse, responsable du Centre National de Référence (CNR) de la Coqueluche à l’Institut Pasteur, « cette flambée s’explique par plusieurs facteurs interconnectés : l’effet cyclique de la maladie et les variations antigéniques facilitant l’échappement immunitaire.
Cette épidémie a révélé un phénomène plus préoccupant encore avec l’émergence de souches résistantes aux macrolides, principale classe d’antibiotiques utilisée. » Parmi les 400 souches analysées au CNR, une quinzaine étaient résistantes. « Nous avons découvert que les trois lignées françaises avaient des ancêtres très proches parmi les souches chinoises.»
Cette observation suggère une introduction multiple depuis la Chine, où la situation est aujourd’hui dramatique : « Près de 100 % des souches de coqueluche y sont résistantes aux macrolides, et cette résistance s’étend aussi à d’autres pathogènes, reflétant sans doute un usage excessif et inapproprié des antibiotiques. » Pour mieux détecter ces résistances, le CNR a développé un test moléculaire rapide (qPCR) ciblant la mutation responsable. « Ce test nous a permis d’estimer que le taux de résistance en France est resté faible, 2 à 3 %. »
La vaccination reste le rempart essentiel contre la coqueluche. Chez les adultes et les personnes âgées, des retards dans les rappels recommandés persistent et peuvent entraîner des complications graves.
" La coqueluche : une maladie contagieuse à ne pas sous-estimer ! " - Sylvain Brisse, responsable du Centre National de Référence (CNR) de la Coqueluche à l’Institut Pasteur Crédit : Jeanne Fenouil/ Institut Pasteur
La menace d’une crise sanitaire majeure et mondiale est désormais une réalité
Les conséquences de ces résistances sont graves et constituent un enjeu sanitaire majeur au niveau mondial. Les antimicrobiens perdent leur efficacité et les infections deviennent de plus en plus difficiles, voire impossibles, à traiter. Beaucoup d’actes médicaux reposent sur les antimicrobiens :
- chirurgies lourdes (prothèses, greffes) ;
- traitements du cancer (chimiothérapie) ;
- soins intensifs ou néonataux…
Sans antimicrobiens efficaces, ces interventions deviennent beaucoup plus dangereuses.
Cette crise sanitaire cause déjà 4,95 millions de morts annuels (The Lancet, 2024), et pourrait atteindre 10 millions par an d’ici 2050. Nous risquons entre autres de nous acheminer vers une ère post-antibiotique, où des infections bactériennes courantes redeviendraient mortelles. Cette inquiétante prédiction a éveillé les consciences au plus haut niveau, car la résistance se propage à grande vitesse par les voyages, le commerce, l’agriculture. Un microbe résistant apparu en un point du globe peut rapidement circuler partout. Elle touche tous les pays, riches comme pauvres, et menace ainsi la sécurité sanitaire mondiale.
L’exemple du virus Monkeypox et la résistance au Tecovirimat
Le mpox (anciennement variole du singe ou variole simienne) est une maladie infectieuse causée par le virus Monkeypox. Elle se transmet principalement des rongeurs à l’humain, mais peut aussi se propager entre humains. Depuis 2022, des souches spécifiques sont à l’origine d’importantes épidémies qui se propagent en dehors des zones endémiques d’Afrique centrale et occidentale. Pour traiter les patients infectés, un médicament, appelé Tecovirimat, peut être utilisé. Celui-ci est toutefois inefficace sur certains virus résistants. En 2022, aux États-Unis, environ 1 % des patients traités au Tecovirimat ont ainsi développé des résistances au médicament. Des travaux effectués à l’Institut Pasteur ont permis de comprendre comment les variants portant certaines mutations rendent le traitement antiviral inefficace. Tirant parti des données de structure moléculaire de la protéine virale cible du Tecovirimat, des chercheurs de l’Institut Pasteur, sous la direction de Pablo Guardado-Calvo développent de nouveaux antiviraux qui pourraient agir sur les virus résistants.

Candida auris : l’ennemi invisible des hôpitaux
Identifié en 1996 en Corée du Sud mais décrit comme nouvelle espèce en 2009, Candida auris est aujourd’hui l’un des champignons pathogènes les plus inquiétants. « Son émergence quasi simultanée sur plusieurs continents, sans lien épidémiologique, est frappante », explique Alexandre Alanio, directeur adjoint du Centre National de Référence Mycoses invasives et Antifongiques (CNRMA) de l’Institut Pasteur. Ses premières traces en France remontent à 2007, identifiées rétrospectivement après la mise à jour des bases génomiques par Marie Desnos (directrice adjointe du CNRMA). Depuis, il s’est répandu mondialement, avec des foyers épidémiques signalés dès 2011, notamment en Inde et au Moyen-Orient. « En Europe, les cas sont encore importés, mais on observe une hausse inquiétante, surtout en Europe du Sud et de l’Est, avec des transmissions nosocomiales ».
Candida auris se distingue par sa capacité à coloniser les environnements hospitaliers, persistant sur les surfaces malgré les désinfections. En 2024, un hôpital français a connu un foyer de 25 patients infectés par la même souche, révélant une transmission active. Les services de réanimation sont particulièrement vulnérables, le champignon adhérant aux équipements et résistant aux nettoyages standards. « Même avec des protocoles renforcés, il est difficile à éradiquer », confirme Fanny Lanternier (responsable du CNRMA), soulignant son rôle de réservoir environnemental favorisant les réinfections, surtout chez les patients immunodéprimés.

Sur le plan thérapeutique, Candida auris résiste à plusieurs antifongiques, notamment aux azolés. « En France, les souches restent sensibles aux échinocandines, mais des résistances émergent ailleurs, comme en Amérique du Sud et aux États-Unis », alerte Fanny Lanternier. Le risque de souches multi-résistantes compliquerait encore la prise en charge.
Le CNRMA joue un rôle clé dans la surveillance et la recherche. « Nous séquençons systématiquement les génomes pour tracer les souches et comprendre leur transmission », explique Alexandre Alanio. Ces données, combinées à celles des hygiénistes, permettent d’adapter les protocoles. « Notre priorité est de développer des outils diagnostiques rapides, surtout pour les pays du Sud, où les ressources manquent », insiste-t-il. Fanny Lanternier ajoute : « la recherche sur les mécanismes de résistance est cruciale pour anticiper les crises.»
« Candida auris rappelle que les champignons pathogènes ignorent les frontières. Son émergence est liée à des facteurs globaux, nécessitant une réponse coordonnée », conclut Alexandre Alanio. Pour Fanny Lanternier, « investir dans la recherche et la surveillance est indispensable pour éviter qu’il ne devienne ingérable ». Une mobilisation urgente s’impose pour préserver l’efficacité des traitements et limiter la propagation de ce pathogène insidieux.
L’exemple du champignon Aspergillus : une résistance venue des champs
Le champignon Aspergillus fumigatus est responsable d’infections pulmonaires graves, développant une résistance croissante aux traitements antifongiques azolés (médicaments de référence). En effet, les infections à Aspergillus résistant (jusqu’à 10 % des cas en Europe) augmentent la mortalité chez les patients fragiles (greffés, sous chimiothérapie).
Les travaux d’Alexandre Alanio (Institut Pasteur/ AP-HP), qui a participé comme expert au rapport récent de l’EFSA (Autorité européenne de sécurité des aliments), révèlent que cette résistance émerge largement de l’environnement : l’usage massif de fongicides azolés en agriculture sélectionne des souches mutantes résistantes dans les sols, l’air ou les composts. Ces souches sont ensuite inhalées par l’être humain, compromettant l’efficacité des traitements chez les patients immunodéprimés. Cette résistance est surveillée d’un point de vue national par le Centre National de Référence Mycoses invasives et Antifongiques par Fanny Lanternier (directrice du CNRMA), Dea Garcia-Hermoso et Alexandre Alanio (directeurs adjoints du CNRMA).

Un danger sous-estimé ?
Les résistances aux antiviraux, moins médiatisées que celles aux antibiotiques, sont un défi croissant et sous-estimé dans la lutte contre les infections virales. Comme l’explique Olivier Schwartz, Responsable de l’unité Virus et Immunité à l’Institut Pasteur, « elles constituent un enjeu tout aussi crucial, surtout pour des virus comme le VIH ou le SARS-CoV-2, qui évoluent rapidement ». Les virus accumulent des mutations sous la pression des traitements, échappant ainsi à leur action. Ce phénomène est particulièrement préoccupant pour le VIH, nécessitant des traitements à vie, ou pour le SARS-CoV-2, dont les variants ont rapidement rendu inefficaces les premiers anticorps monoclonaux antiviraux. « Une seule mutation peut suffire à induire une résistance », souligne le chercheur, insistant sur la nécessité d’une surveillance en temps réel.
Pour limiter ce risque, les stratégies reposent sur des combinaisons de molécules, comme les trithérapies contre le VIH. Le séquençage génomique permet aussi de détecter précocement les mutations résistantes et d’adapter les protocoles thérapeutiques. L’intelligence artificielle offre de nouvelles perspectives en prédisant les résistances et en concevant des antiviraux plus robustes. Olivier Schwartz insiste : « Sans une compréhension fine de la biologie virale, impossible de développer des traitements durables .» Une approche proactive est indispensable pour préserver l’efficacité de ces traitements essentiels. «Il faut anticiper ces résistances, en diversifiant nos outils thérapeutiques et en renforçant la surveillance des souches virales », résume Olivier Schwartz.

L’artémisinine en difficulté contre des parasites de plus en plus résistants au paludisme
Plasmodium falciparum, responsable de la forme la plus mortelle du paludisme, pose aujourd’hui un défi majeur : la résistance croissante aux antipaludiques, en particulier à l’artémisinine, composant central des thérapies combinées qui constituent le traitement de référence. Ce phénomène, apparu en Asie du Sud-Est dans les années 2000, est désormais également observé en Afrique, où 90 % des cas de paludisme sont recensés, en raison de l’émergence locale de parasites résistants.
Cette résistance, décryptée grâce à l’identification du marqueur génétique K13, constitue une menace croissante : les mutations de ce gène ralentissent l’élimination de ce parasite dans le sang, ce qui réduit l’efficacité des traitements. En Guyane, seul territoire avec transmission autochtone active (quelques centaines de cas annuels), le Centre National de Référence du Paludisme surveille intensivement ces mutations pour prévenir leur émergence et leur diffusion dans les foyers forestiers. Dans les DROM Martinique, Guadeloupe, Mayotte), où le paludisme avait été éliminé, la résistance représente un risque de réintroduction via les cas importés d’Afrique ou d’Asie, combiné la présence de moustiques vecteurs compétents.

endif; ?>Les infections fongiques méritent qu’on y consacre plus de moyens, car elles sont potentiellement graves et difficiles à traiter.
Les champignons pathogènes sont souvent méconnus. Quelle est leur importance en santé humaine ?
Certains champignons sont responsables d’infections graves chez l’humain. Chaque année, 1,6 à 2,6 millions de personnes meurent dans le monde à cause d’infections fongiques, et des milliards d’autres sont touchées par des infections cutanées ou systémiques. Ces chiffres sont comparables à ceux de la tuberculose ou de certains cancers, et pourtant, les champignons pathogènes restent l’un des parents pauvres de la recherche : moins de 3 % du budget mondial consacré aux maladies infectieuses leur est dédié.
Ces infections concernent tout le monde. Les champignons pathogènes sont partout : dans l’air que nous respirons, sur notre peau, et même dans notre système digestif. Ils font partie de notre environnement, mais peuvent devenir redoutables dans certaines conditions.
Quels sont les champignons les plus préoccupants aujourd’hui ?
Quatre espèces se distinguent par leur dangerosité et leur impact sur la santé publique. Cryptococcus neoformans est un champignon étudié de près par mon laboratoire. Il est responsable de méningites graves, notamment chez les personnes dont le système immunitaire est affaibli. Sans traitement, ces infections peuvent être mortelles.
Candida albicans fait naturellement partie de notre microbiote, notamment au niveau de la peau, du tube digestif ou des muqueuses. En temps normal, il est inoffensif, mais en cas de déséquilibre de notre flore microbienne, il peut provoquer des infections sévères, comme des candidémies (infections du sang) ou des infections profondes difficiles à traiter.
Aspergillus fumigatus est un champignon que nous respirons quotidiennement sous forme de spores, sans danger pour la plupart d’entre nous. Cependant, chez les personnes fragilisées, il peut causer une aspergillose pulmonaire, une infection grave qui détruit les tissus des poumons et résiste souvent aux traitements antifongiques classiques.
Enfin, Candida auris est un champignon qui préoccupe beaucoup la communauté scientifique et médicale. Apparu seulement après 2005, il n’était pas connu comme pathogène avant cette date. Aujourd’hui, il est responsable d’épidémies nosocomiales (infections acquises à l’hôpital) dans de nombreux pays.
Comment les champignons deviennent-ils résistants aux antifongiques ?
La résistance aux antifongiques est un phénomène complexe, qui repose sur deux mécanismes principaux. Le premier est la résistance naturelle. Cela signifie qu’ils possèdent des caractéristiques génétiques qui les protègent dès le départ. Le second mécanisme est la résistance acquise. Elle se développe au fil du temps, notamment chez les patients qui suivent des traitements prolongés avec des antifongiques. Sous cette pression, les champignons mutent et deviennent résistants. Un autre facteur aggrave le problème : l’utilisation massive d’antifongiques en agriculture. Les mêmes classes de molécules sont employées pour protéger les cultures et soigner les humains. Cette utilisation intensive favorise l’émergence de souches résistantes, qui peuvent ensuite infecter l’humain.
Quels traitements existe-t-il contre les infections fongiques ?
Actuellement, nous disposons de quatre grandes classes d’antifongiques pour traiter les infections fongiques :
- Polyènes ;
- Azolés ;
- Échinocandines ;
- 5-fluorocytosine.
De nouvelles molécules sont en développement, mais ces molécules risquent, elles aussi, d’être utilisées en agriculture, ce qui pourrait accélérer l’émergence de nouvelles résistances. Le grand absent dans notre arsenal thérapeutique, c’est le vaccin. Contrairement aux bactéries ou aux virus, aucun vaccin n’existe aujourd’hui pour prévenir les infections fongiques.
Le changement climatique influence-t-il les infections fongiques ?
Oui, et c’est l’une de nos principales préoccupations. Le réchauffement climatique pourrait élargir la répartition géographique de certains champignons. Candida auris est un cas d’école. Son apparition soudaine dans plusieurs pays suggère qu’il pourrait s’être adapté à des températures plus élevées, peut-être en raison du réchauffement climatique. Si cette hypothèse se confirme, nous pourrions assister à l’émergence d’autres champignons pathogènes dans les années à venir.
Peut-on craindre une pandémie fongique, comme celle que nous avons connue avec le Covid-19 ?
Une pandémie fongique à l’échelle du Covid-19 est peu probable, car les champignons ne se transmettent pas aussi facilement que les virus. Le scénario le plus inquiétant serait l’apparition d’un champignon à la fois résistant, virulent et transmissible. Bien que cela reste improbable, les scientifiques et les médecins surveillent de près les émergences fongiques, car une telle situation pourrait poser un défi majeur pour la santé publique.
Surveiller les marqueurs de résistance
La résistance à l’artémisinine, traitement clé contre le paludisme, est principalement due à des mutations du gène Kelch13. Ces mutations réduisent la capacité du parasite à absorber l’hémoglobine, limitant ainsi la libération de fer ferreux (Fe²⁺), essentiel pour activer le médicament. En bloquant ce mécanisme, le parasite affaiblit l’effet de l’artémisinine, comme s’il « désamorçait une bombe », selon Didier Ménard, professeur à l’Université de Strasbourg et chercheur à l’Institut Pasteur. Mais la résistance ne s’arrête pas là : « même au sein d’une population génétiquement identique, on observe une hétérogénéité des souspopulations. Certaines d’entre elles adoptent un programme cellulaire spécifique qui leur confère la capacité de résister à l’exposition à l’artémisinine. »
Contrairement aux craintes initiales, la résistance observée en Afrique n’est pas liée à l’importation de souches asiatiques, mais résulte d’une émergence locale et indépendante. « Ce qui est préoccupant, c’est que ces résistances apparaissent sans lien entre les régions, ce qui complique leur contrôle », souligne le chercheur. Un autre défi est la perte du gène hrp2 chez certains parasites, les empêchant de produire la protéine HRP2, cible des tests de diagnostic rapide. Conséquence : les tests peuvent donner des résultats négatifs chez des personnes infectées, retardant ou empêchant une prise en charge adaptée. Pour contrer cette impasse thérapeutique, plusieurs approches sont déployées : diversification des traitements avec des combinaisons médicamenteuses, et surveillance accrue grâce à la détection précoce des résistances via des marqueurs moléculaires et des tests in vitro.

Globule rouge humain infecté par Plasmodium falciparum observé par microscopie électronique à balayage. Image colorisée - Crédit :Institut Pasteur/Aurélie Claës - colorisation Jean-Marc Panaud
Comment inverser la tendance de dissémination de la résistance aux antimicrobiens ?
La lutte contre les résistances aux antimicrobiens (RAM) nécessite une approche coordonnée des chercheurs, médecins et vétérinaires. La santé des humains, des animaux et de l’environnement sont étroitement liées et doivent être protégées ensemble pour prévenir les maladies, concept de « One Health » ou Santé Globale. Face à la dissémination mondiale des gènes de résistance (par exemple via les eaux usées ou le commerce international) et sans réponse holistique, nous risquons un retour à l’ère où des infections banales redeviendront mortelles, alerte l’OMS (Organisation Mondiale de la Santé). Une recherche multidisciplinaire de pointe et des approches intégrées sont mises en place – épidémiologie, génomique, biologie évolutive, modélisation, biologie structurale et chimique – pour décrypter comment émergent et se diffusent les résistances chez les micro-organismes, ainsi que leur interaction avec l’organisme hôte. Grâce à ses centres d’alertes précoces (avec la présence de Centres Nationaux de Référence), l’Institut Pasteur contribue à la surveillance des résistances émergentes, avec la mise au point de capteurs nano-électroniques pour détecter la résistance aux antibiotiques en trois minutes ou de tests génomiques pour anticiper les résistances du VIH ou du paludisme. Les chercheurs étudient également les stratégies d’échappement thérapeutique favorisant la résistance, notamment au sein des biofilms (communauté de microbes qui s’agrègent et s’attachent à une surface vivante ou inerte, en produisant une matrice protectrice de substances visqueuses). Les microbes d’un biofilm peuvent être 100 à 1 000 fois plus résistants aux antimicrobiens qu’à l’état libre. Enfin, les chercheurs développent des alternatives thérapeutiques (phagothérapie, peptides anti-microbiens, combinaison de médicaments, anticorps bispécifiques).
L’objectif est de contribuer sans relâche au développement de stratégies thérapeutiques innovantes (antibiotiques, antiparasitaires, antifongiques, antiviraux, antivecteurs) afin d’assurer des traitements des maladies infectieuses plus sûrs et durables.





